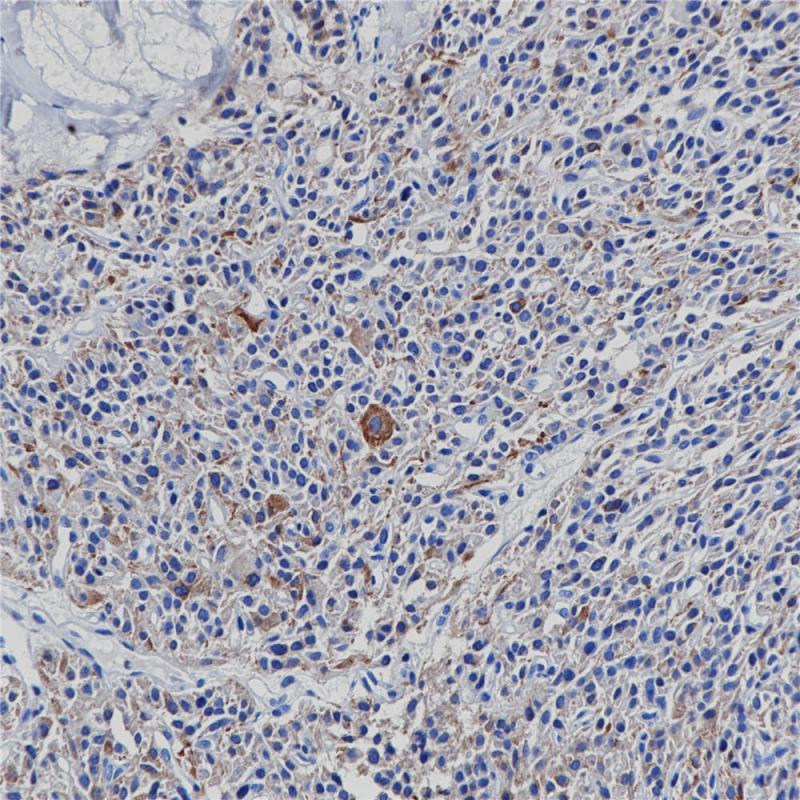
甲状腺滤泡癌BP6128(Calcitonin)染色

产品中心
甲状腺滤泡癌BP6128(Calcitonin)染色
Calcitonin 重组兔单克隆抗体
降钙素(calcitonin,CT)是由甲状腺滤泡旁细胞(C细胞)分泌的一种多肽激素,分子量为350kDa,其主要应用于甲状腺C细胞增生、甲状腺髓样癌的诊断,在部分神经内分泌细胞肿瘤会有阳性表达。
Specifications
- 目录号
- BX50124
- 克隆号
- BP6128
- 阳性对照
- 甲状腺髓样癌
- 亚细胞定位
- 细胞质
- 组织类型
- FFPE
- 修复方式
- HIER
- 稀释比
- 1:100-1:200
- 规格
- 100μl/vial, 1ml/vial
- 用途
- RUO
Reference
1.Xing R et al. Int J Mol Med 38:1125-34 (2016).
2.Ramasamy SK et al. Nat Commun 7:13601 (2016).


